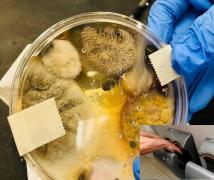
Uscătoarele de mâini, un pericol public? O postare virală te poate face să te gândești de două ori înainte să le folosești (Foto)

Experiment Observator. Cum arată viaţa fără curent, fără tehnologie şi căldură
Experiment Observator. Cum arată viaţa fără curent, fără tehnologie şi căldurăAţi rezista o zi fără curent electric? Dar trei zile? O săptămână? O pană de curent care ar opri şi furnizarea gazelor sau...
pe 24.01.2019 la 22:15
Experiment Observator. Cât de des spun românii "Mulţumesc"
Experiment Observator. Cât de des spun românii "Mulţumesc"Stresaţi şi mereu pe fugă, oamenii uită să mai spună "mulţumesc" în faţa unor gesturi simple. Un cuvânt care...
pe 11.01.2019 la 21:55
Experiment. Ce fac românii când găsesc un card bancar cu PIN-ul scris la vedere
Experiment. Ce fac românii când găsesc un card bancar cu PIN-ul scris la vedereO avere găsită în mijlocul străzii este o capcană sau o şansă la îmbogăţire uşoară? Reporterii Observator au încercat...
pe 11.01.2019 la 16:34
Ce s-ar fi întâmplat dacă Donald Trump nu ajungea președinte
Ce s-ar fi întâmplat dacă Donald Trump nu ajungea președinteUltima emisiune "Saturday Night Live" din acest an a fost un exerciţiu de imaginaţie. Show-ul a creat o lume în care Donald Trump...
pe 16.12.2018 la 21:41
Românii spun că citesc, dar rămân cu lăudatul. Suntem pe ultimul loc în Europa la piaţa de carte
Românii spun că citesc, dar rămân cu lăudatul. Suntem pe ultimul loc în Europa la piaţa de carteSpun că citesc, dar rămân doar cu lăudatul. Deşi mai bine de o treime dintre români răspund "citesc" atunci când sunt...
pe 11.10.2018 la 10:32
Experiment Observator: Zâmbetul, cel mai eficient tratament anti-stres
Experiment Observator: Zâmbetul, cel mai eficient tratament anti-stresEste cel mai plăcut tratament anti-stres, nu costă nimic şi îi poate molipsi pe ceilalţi. Un simplu zâmbet face minuni pentru...
pe 05.10.2018 la 21:02
Experiment Observator: Cât durează parcurgerea celor 70 de kilometri, pe Centura Capitalei
Experiment Observator: Cât durează parcurgerea celor 70 de kilometri, pe Centura CapitaleiOficialii se ceartă pe şoseaua de centură a Capitalei, iar şoferii stau blocaţi cu orele în trafic. În timp ce...
pe 07.09.2018 la 21:09
Experiment Observator: milionar la colțul străzii. Cui dau românii bani pe stradă
Experiment Observator: milionar la colțul străzii. Cui dau românii bani pe stradăSă aduni un milion de lei în România, de pe stradă, poate fi misiune imposibilă, dar dacă insişti s-ar putea să-ţi iasă....
pe 19.07.2018 la 19:39
Experiment: Cine e mai rapid în Capitală. Cu motocicleta, distanța a fost parcursă în doar opt minute
Experiment: Cine e mai rapid în Capitală. Cu motocicleta, distanța a fost parcursă în doar opt minutePe jos, pe două roţi sau cu maşina? E întrebarea pe care şi-o pun tot mai mulţi români, rezidenţi ai celor mai aglomerate...
pe 28.06.2018 la 02:26
Prietenii la nevoie se cunosc în Vama Veche. E locul de pe litoral unde este imposibil să rămâi singur la greu
Prietenii la nevoie se cunosc în Vama Veche. E locul de pe litoral unde este imposibil să rămâi singur la greupe 01.05.2018 la 07:44

Experiment Observator: chetă pentru o zi, în Vama Veche. Reacţiile neaşteptate ale oamenilor
Experiment Observator: chetă pentru o zi, în Vama Veche. Reacţiile neaşteptate ale oamenilorPrietenii la nevoie se cunosc în Vama Veche. E locul de pe litoral unde este imposibil să rămâi singur la greu. O dovedeşte un...
pe 30.04.2018 la 19:24
Experiment Observator: cum e viața fără smartphone
Experiment Observator: cum e viața fără smartphoneAţi putea renunţa chiar şi pentru câteva zeci de minute la telefonul mobil? Dar la cardul bancar, la internet şi la tot ceea ce...
pe 13.04.2018 la 19:29
Experiment Observator: românii semnează ca primarul, fără să citească înainte actele
Experiment Observator: românii semnează ca primarul, fără să citească înainte acteleScandalul enorm declanşat de furtul informaţiilor personale prin intermediul reţelei Facebook nu îi determină pe români să...
pe 22.03.2018 la 19:12
Un experiment Observator ne arată care sunt cele mai murdare locuri dintr-un supermarket
Un experiment Observator ne arată care sunt cele mai murdare locuri dintr-un supermarketDe la cumpărături nu pleci doar cu produsele pe care le-ai plătit, ci şi cu bacterii.
pe 07.03.2018 la 19:23
Experimentul neobişnuit al unui elev a avut un final nefericit, la Galaţi
Experimentul neobişnuit al unui elev a avut un final nefericit, la GalaţiCuriozitatea era să-l coste viaţa pe un elev de 15 ani din Galaţi! Adolescentul a vrut să facă un experiment văzut cel mai...
pe 23.02.2018 la 16:03
Românii nu vor să renunţe la cash, deşi sunt 17 milioane de carduri în ţară
Românii nu vor să renunţe la cash, deşi sunt 17 milioane de carduri în ţarăSuntem 19 milioane de locuitori în ţară, conform ultimelor statistici, şi folosim 17 milioane de carduri bancare.
pe 19.02.2018 la 19:33
O echipă de cercetători din Israel testează condiţiile de viaţă de pe Marte chiar pe Pământ
O echipă de cercetători din Israel testează condiţiile de viaţă de pe Marte chiar pe PământPrintr-un experiment ce pare desprins din filmul Marţianul, savanţii au încercat să simuleze. existenţa pe Planeta Roşie şi...
pe 19.02.2018 la 07:34
Experiment. Cum reacționează oamenii în fața unor dovezi de iubire
Experiment. Cum reacționează oamenii în fața unor dovezi de iubireÎn Ziua Internaţională a Îndrăgostiţilor, echipa Observator a vrut să vadă dacă românii mai au timp de iubire.
pe 14.02.2018 la 19:25
Uscătoarele de mâini, un pericol public? O postare virală te poate face să te gândești de două ori înainte să le folosești (Foto)
Uscătoarele de mâini, un pericol public? O postare virală te poate face să te gândești de două ori înainte să le folosești (Foto)O postare devenită virală te poate face să te gândești de două ori înainte să folosești uscătoarele de mâini din...
pe 09.02.2018 la 00:45
Experiment cu o cameră ascunsă. Ce fac românii când găsesc pe stradă un portofel
Experiment cu o cameră ascunsă. Ce fac românii când găsesc pe stradă un portofelUn portofel pierdut pe stradă devine, în România, câştigul celui care îl găseşte. Un experiment al reporterilor Observator.
pe 28.01.2018 la 19:25
Experiment unic în ţară! Legume crescute în îngrășăminte de la pești
Experiment unic în ţară! Legume crescute în îngrășăminte de la peștiUn experiment unic în ţară a fost pus la punct de un liceu din Ardeal! Acolo, plantele sunt cultivate cu ajutorul apei din...
pe 14.11.2017 la 16:28
Din chilie, direct pe plajă! 5 tinere au celebrat în bikini, în faţa călugăriţelor, încheierea stagiului la o mănăstire
Din chilie, direct pe plajă! 5 tinere au celebrat în bikini, în faţa călugăriţelor, încheierea stagiului la o mănăstireUn experiment al unei televiziuni britanice s-a încheiat cu totul neaşteptat. Timp de o lună, 5 fete petrecăreţe au fost...
pe 10.11.2017 la 18:07
Experiment OBSERVATOR: Militar pentru o zi. Oamenii obişnuiţi au învăţat cum să prindă terorişti
Experiment OBSERVATOR: Militar pentru o zi. Oamenii obişnuiţi au învăţat cum să prindă teroriştiOamenii obişnuiţi au devenit militari profesionişti pentru câteva ore, într-un exerciţiu inedit pus la cale de Ziua Armatei.
pe 25.10.2017 la 20:04
EXPERIMENT Cum să scapi dintr-o maşină scufundată sau distrusă
EXPERIMENT Cum să scapi dintr-o maşină scufundată sau distrusă30 de secunde, maximum un minut. Atât au la dispoziţie pasagerii unei maşini care se scufundă, să îşi salveze viaţa.
pe 09.10.2017 la 19:11
Experiment inedit al polițiștilor rutieri din Buzău! Ochelarii care îţi "îmbată" privirea
Experiment inedit al polițiștilor rutieri din Buzău! Ochelarii care îţi "îmbată" privireaExperiment inedit al polițiștilor rutieri din Buzău! Aceştia i-au pus pe cursanţii şcolilor de şoferi să probeze o pereche...
pe 06.10.2017 la 16:40
S-a demonstrat: bărbaţii nu observă schimbările
S-a demonstrat: bărbaţii nu observă schimbărileSe spune că bărbaţii nu sunt atenţi la detalii. Un experiment inedit a arătat că nici măcar atunci când în faţa lor apar...
pe 03.10.2017 la 19:48
Experiment. Când montăm anvelopele de iarnă
Experiment. Când montăm anvelopele de iarnăPână la finalul "procesului de pregătire", orice şofer îşi poate lua propriile măsuri de precauţie.
pe 27.09.2017 la 19:37
Experiment Observator: cât de distructivă e forţa unui uragan
Experiment Observator: cât de distructivă e forţa unui uraganIrma este unul dintre cele mai puternice uragane formate vreodată în Atlantic. Rafalele de vânt de aproape 300 km/h plasează...
pe 07.09.2017 la 19:11
Medicul Burnei, în fața judecății pacienților! Zeci de familii suferă acum în urma experimentelor făcute de el
Medicul Burnei, în fața judecății pacienților! Zeci de familii suferă acum în urma experimentelor făcute de elŞi-au pus toate speranţele în mâna marelui profesor, dar au primit o lovitură mai dureroasă decât boala. Zeci de familii...
pe 30.08.2017 la 19:17
Un experiment Observator realizat alături de scafandri a demonstrat că poţi scăpa de înec atunci când eşti prins de curenţi
Un experiment Observator realizat alături de scafandri a demonstrat că poţi scăpa de înec atunci când eşti prins de curenţiMarea Neagră a luat în această vară 21 de vieţi - patru de copil. Principalul motiv - turiştii nu ţin cont de sfaturile...
pe 25.08.2017 la 19:27
Marea a luat 21 de vieţi pe Litoral în această vară, iar o echipă Observator participat la un experiment alături de salvatorii de la ISU
Marea a luat 21 de vieţi pe Litoral în această vară, iar o echipă Observator participat la un experiment alături de salvatorii de la ISUMarea Neagră a înghiţit, vara aceasta, 21 de vieţi. Printre victime sunt şi patru copii. Ar exista şi o explicaţie...
pe 25.08.2017 la 16:38
VIDEO: Experiment INEDIT realizat de un student la Politehnică. Melodia "Thunderstruck", a celor de la AC/DC, a fost transformată în fulgere
VIDEO: Experiment INEDIT realizat de un student la Politehnică. Melodia "Thunderstruck", a celor de la AC/DC, a fost transformată în fulgereDaniel Ghilinţă, un student la Facultatea de Automatică și Calculatoare, din cadrul Universităţii Politehnica din Bucureşti,...
pe 09.05.2017 la 18:37
Cât ar rezista un bărbat durerilor provocate de naştere? Un student a aflat răspunsul la această întrebare VIDEO
Cât ar rezista un bărbat durerilor provocate de naştere? Un student a aflat răspunsul la această întrebare VIDEOUn student a luat parte la un experiment, în cadrul căruia a experimentat durerile unei naşteri. El a luat această decizie,...
pe 26.04.2017 la 13:04
Meseria de controlor RATB este una dintre cele mai stresante. Au aflat-o şi reporterii Observator
Meseria de controlor RATB este una dintre cele mai stresante. Au aflat-o şi reporterii ObservatorÎn transportul în comun nervii nu rezistă. Nici ai călătărilor, nici ai controlorilor. Pentru un drum. gratis izbucnesc...
pe 05.04.2017 la 19:29
A îndurat tăieturi pe piele, spini de trandafiri înfipţi în abdomen şi un pistol îndreptat spre tâmplă: Povestea Marinei Abramović, femeia care a văzut moartea de multe ori (FOTO + VIDEO)
A îndurat tăieturi pe piele, spini de trandafiri înfipţi în abdomen şi un pistol îndreptat spre tâmplă: Povestea Marinei Abramović, femeia care a văzut moartea de multe ori (FOTO + VIDEO)Câţi dintre noi nu ne-am înfuriat pe ceilalţi, fără a avea un motiv bine întemeiat? Sau câţi dintre noi nu am devenit...
pe 07.11.2016 la 18:52
Strigăt de ajutor ignorat! Copil pierdut, lăsat fără sprijin
Strigăt de ajutor ignorat! Copil pierdut, lăsat fără sprijinIn fiecare zi, 10 dintre copii dispar. E o statistică extrem de dură la care fiecare dintre noi pare să contribuie. O dovedeşte...
pe 08.09.2016 la 19:16
Experiment de speriat părinţii. Cât timp le ia copiilor să realizeze că părinţii nu mai sunt în casă şi că în locul lor sunt nişte străini?
Experiment de speriat părinţii. Cât timp le ia copiilor să realizeze că părinţii nu mai sunt în casă şi că în locul lor sunt nişte străini?Cât timp le ia copiilor să realizeze că părinţii lor nu mai sunt în casă şi că în locul lor sunt nişte străini? E un...
pe 08.09.2016 la 16:57
Premieră mondială! Un rus va fi DECAPITAT, iar capul va fi lipit de alt corp. Operaţia, care va dura două zile, este cel mai SCANDALOS experiment pe oameni
Premieră mondială! Un rus va fi DECAPITAT, iar capul va fi lipit de alt corp. Operaţia, care va dura două zile, este cel mai SCANDALOS experiment pe oameniValery Spiridonov are boala Werdnig-Hoffman, o maladie rară şi incurabilă care atrofiază musculatura spinală. Boala fiindu-i...
pe 18.08.2016 la 20:17
Aţi avea curaj să faceţi un astfel de test? Experimentul care ne arată dacă suntem cu adevărat îndrăgostiți
Aţi avea curaj să faceţi un astfel de test? Experimentul care ne arată dacă suntem cu adevărat îndrăgostițiO echipă de cercetători spanioli asigură că a descoperit o modalitate de a demonstra științific dragostea dintre doi oameni,...
pe 30.05.2016 la 09:20
EXPERIMENT: Cum a murit Dan Condrea, patronul Hexi Pharma
EXPERIMENT: Cum a murit Dan Condrea, patronul Hexi PharmaNimeni nu ar fi putut supravieţui violenţei accidentului de aseară! La peste 150 de kilometri pe oră, cu cât au spus martorii...
pe 23.05.2016 la 19:13
Cei patru tineri din Timiş, răniţi de explozia unui televizor, făceau un experiment cu droguri şi ulei de cannabis
Cei patru tineri din Timiş, răniţi de explozia unui televizor, făceau un experiment cu droguri şi ulei de cannabisUn experiment cu droguri şi ulei de cannabis a aruncat pur şi simplu o casă în aer. Este vorba despre casa unui traficant...
pe 11.05.2016 la 19:09
Un profesor de fizică din Buzău a murit electrocutat în faţa elevilor săi
Un profesor de fizică din Buzău a murit electrocutat în faţa elevilor săiUn profesor de fizică din Buzău a murit în faţa elevilor săi, în timpul unui experiment scăpat de sub control. Dascălul s-a...
pe 13.04.2016 la 19:10
Elevii se pot juca cu ştiinţa, în prima casă a experimentelor dedicată lor
Elevii se pot juca cu ştiinţa, în prima casă a experimentelor dedicată lorEste locul ideal, unde elevii pot pune în practică teoriile din manualele de matematică sau fizică. Proiectul este unic în...
pe 31.01.2016 la 19:42
Experiment: Cine ajută un om fără casă când îi este frig
Experiment: Cine ajută un om fără casă când îi este frigGerul muşcă şi în următoarele zile. Ne-aşteaptă un weekend rece, cu minime de minus 22 de grade Celsius. Trei oameni au murit...
pe 23.01.2016 la 19:18
Experiment: Românii nu sunt pregătiţi să înfrunte gerul
Experiment: Românii nu sunt pregătiţi să înfrunte gerulUn experiment realizat cu o cameră cu termoviziune demonstrează însă că nu suntem pregătiţi să înfruntăm gerul.
pe 20.01.2016 la 16:15
A fost readus la viață după ce a fost congelat peste 30 de ani. Lumea științifică este UIMITĂ!
A fost readus la viață după ce a fost congelat peste 30 de ani. Lumea științifică este UIMITĂ!O echipă de cercetători japonezi a reușit să readucă la viața o creatură marină care a fost congelată timp de 30 de ani
pe 19.01.2016 la 09:10
Cătălin Grădinariu, unul dintre răniţii de la Colectiv, protagonistul unui experiment în premieră mondială
Cătălin Grădinariu, unul dintre răniţii de la Colectiv, protagonistul unui experiment în premieră mondialăDin fericire, unii dintre răniţii din tragedia de la Colectiv au parte şi de momente de bucurie.Cătălin Grădinariu, unul...
pe 15.12.2015 la 19:26
Și-a pus mâinile în oțet de două ori pe săptămână. Rezultatul? Nici ei nu i-a venit să creadă
Și-a pus mâinile în oțet de două ori pe săptămână. Rezultatul? Nici ei nu i-a venit să creadăO femeie care și-a pus mâinile și picioarele în oțet de două ori pe săptămână susține că a scăpat de durerile...
pe 09.12.2015 la 16:14
Nu a mai pus gura pe apă de patru ani. Ce s-a întâmplat cu organismul său
Nu a mai pus gura pe apă de patru ani. Ce s-a întâmplat cu organismul săuAmericanul Peter Filak are 26 de ani şi susţine că din luna mai a anului 2012 nu a mai pus în gură strop de apă
pe 09.11.2015 la 14:20
Zeci de clujeni şi-au dat întâlnire într-un parc să se privească în ochi
Zeci de clujeni şi-au dat întâlnire într-un parc să se privească în ochiSe spune că ochiii sunt oglinda sufletului. În zielele noastre însă, din grabă, ruşine sau emoţie, mulţi oamenii evită să...
pe 16.10.2015 la 07:00

